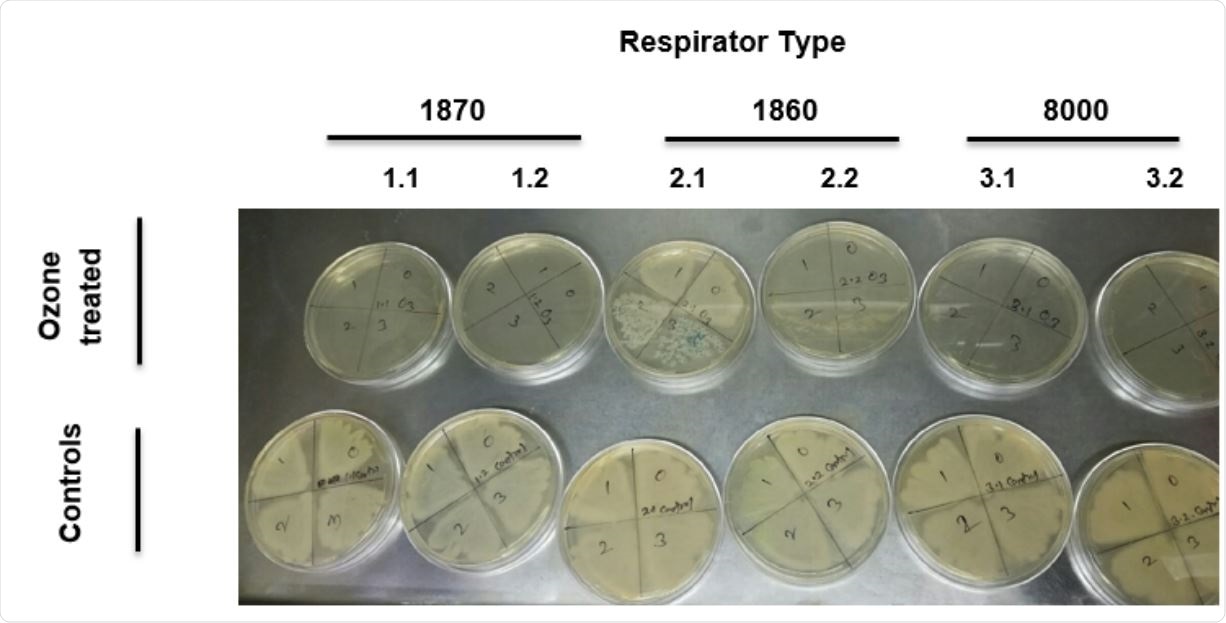
Top row: cultures from respirators inoculated with bacteria culture, exposed to 400 ppm ozone 80% humidity for two hours, and incubated for 24 hours. Bottom row: cultures from respirators inoculated with bacterial culture, exposed to ambient air 35% humidity for two hours, and incubated for 24 hours. Columns are labeled to identify respirator types tested. Tests were performed in duplicate for each respirator type. Serial dilutions were performed to enumerate the numbers of live bacteria.

The development could be used to address a shortage in the availability of this critical piece of personal protective equipment, caused by the COVID-19 crisis.
The authors say that, to their knowledge, their study is the first to report successful disinfection of the masks with ozone and the first to identify the conditions necessary to do so, without damaging mask function.
A preprint version of the paper is available on the server medRxiv*, while the article undergoes peer review.
Supplies of the masks are dwindling
Supplies of the NIOSH-certified N95 filtering facepiece respirators (commonly shortened to“N95 respirators”) have dwindled with the increasing strain placed on healthcare systems due to the COVID-19 pandemic.
This had prompted front-line medical workers to resort to reusing the respirators and experimenting with their own methods of disinfection, which some researchers have described as generally ineffective and damaging to filter performance.
“These events highlight the need for institutions to address the gap in access to effective disinfection equipment for the reuse of N95 respirators, which are needed to ensure the safety of the healthcare workforce,” writes Edward Manning (Department of Internal Medicine, Yale School of Medicine) and colleagues.
What does the CDC say?
The Centers for Disease Control (CDC) has recognized that the reuse of personal protective equipment such as N95 respirators may be necessary to protect healthcare personnel and to lower the risk of transmitting infection in the workplace.
However, the organization says four essential points must be addressed when considering potential ways to achieve this. The method must be effective at killing the organisms being targeted; must not degrade the function of the equipment; must not introduce new risks to healthcare workers and must be practical in the setting of emergency pandemics such as COVID-19, where resources may be too limited to ensure adequate supplies of the equipment.
Some organizations have described potential protocols, including disinfection with dry heat or using vaporized hydrogen peroxide (VHP) and UV-C light.
Ozone is an appealing option
However, Manning and colleagues were interested in the possibility of disinfecting the respirators with ozone as an alternative for healthcare personnel who may not have access to VHP or other disinfection devices.
The team says that not only is ozone attractive as a potential disinfector because it is a strong oxidant that can deactivate viruses, but it can be generated from air, can quickly be destroyed, and does not leave any residue.
Now, the researchers have tested using ozone to kill Pseudomonas aeruginosa on three types of N95 respirators, namely the 3M 1860, 3M 1870, and 3M 8000.
They point out that P. aeruginosa is a bacterium that the CDC has previously referred to as more difficult to kill than viruses such as severe acute respiratory syndrome coronavirus 2 (SARS-CoV-2).
Top row: cultures from respirators inoculated with bacteria culture, exposed to 400 ppm ozone 80% humidity for two hours, and incubated for 24 hours. Bottom row: cultures from respirators inoculated with bacterial culture, exposed to ambient air 35% humidity for two hours, and incubated for 24 hours. Columns are labeled to identify respirator types tested. Tests were performed in duplicate for each respirator type. Serial dilutions were performed to enumerate the numbers of live bacteria.

 This news article was a review of a preliminary scientific report that had not undergone peer-review at the time of publication. Since its initial publication, the scientific report has now been peer reviewed and accepted for publication in a Scientific Journal. Links to the preliminary and peer-reviewed reports are available in the Sources section at the bottom of this article. View Sources
This news article was a review of a preliminary scientific report that had not undergone peer-review at the time of publication. Since its initial publication, the scientific report has now been peer reviewed and accepted for publication in a Scientific Journal. Links to the preliminary and peer-reviewed reports are available in the Sources section at the bottom of this article. View Sources
The ozone disinfector the team used
The device comprised an airtight chamber than could generate ozone from ambient air at a concentration of 500 parts per million (ppm). This ozone UV analyzer could accurately determine ozone levels in the chamber and an ozone destruction unit.
The team reports that exposing the respirator to ozone at a concentration of 400ppm at a humidity of 80% over two hours successfully killed bacteria on all three types of respirators.

Image of N95 respirator after ten treatments with 450 ppm ozone for 2 hours at 75-90% humidity. There is little noticeable wear on the respirator after extended exposure to ozone.
Furthermore, exposure to ozone at this concentration with a relative humidity of 75-90% at room temperature did not degrade the filtration capability of the 1860 and 1870 type respirators for up to 10 cycles of two-hour treatments.
“This study demonstrates that an ozone application achieves a high level of disinfection against PsA [P. aeruginosa], a vegetative bacteria that the CDC identifies as more difficult to kill than medium-sized viruses such as SARS-CoV-2 (Covid-19),” writes the team. “Moreover, ozone presents minimal risk to healthcare personnel or to the environment when used in professionally constructed sealed chamber devices with ozone monitoring and destruction equipment.”
A practical way to decontaminate the respirators
Manning and colleagues advise that ozone disinfection using the small devices could serve as an effective way to decontaminate N95 respirators, especially in rural areas and in cases where healthcare workers and institutions have no access to large-scale disinfection facilities.

Picture of prototype ozone chamber inside fume hood for kill efficacy testing
They point out that the generators needed are already available and that the guidelines already in place for institutions could be tailored for use with the ozone devices.
“Ozone decontamination may be an effective tool to extend the life and usage cycles for N95 respirators during the current pandemic and in future crises,” concludes the team.

 This news article was a review of a preliminary scientific report that had not undergone peer-review at the time of publication. Since its initial publication, the scientific report has now been peer reviewed and accepted for publication in a Scientific Journal. Links to the preliminary and peer-reviewed reports are available in the Sources section at the bottom of this article. View Sources
This news article was a review of a preliminary scientific report that had not undergone peer-review at the time of publication. Since its initial publication, the scientific report has now been peer reviewed and accepted for publication in a Scientific Journal. Links to the preliminary and peer-reviewed reports are available in the Sources section at the bottom of this article. View Sources